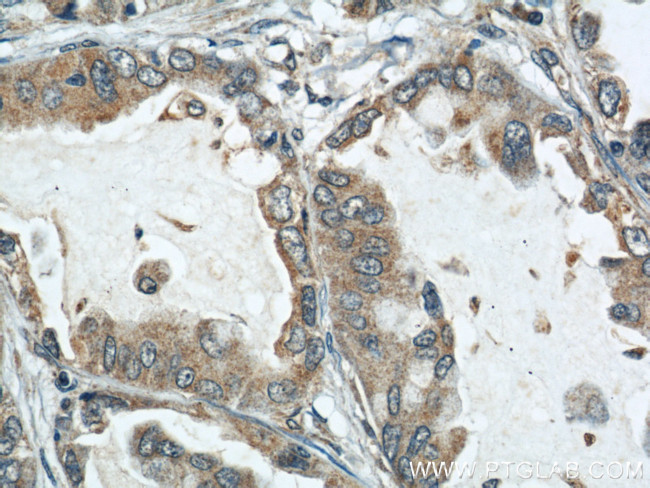
ARPC4 Antibody in Immunohistochemistry (Paraffin) (IHC (P))
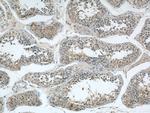
ARPC4 Antibody in Immunohistochemistry (Paraffin) (IHC (P))
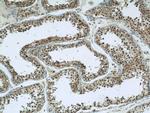
ARPC4 Antibody in Immunohistochemistry (Paraffin) (IHC (P))

Search
Proteintech
ARPC4 Polyclonal Antibody
{{$productOrderCtrl.translations['antibody.pdp.commerceCard.promotion.promotions']}}
{{$productOrderCtrl.translations['antibody.pdp.commerceCard.promotion.viewpromo']}}
{{$productOrderCtrl.translations['antibody.pdp.commerceCard.promotion.promocode']}}: {{promo.promoCode}} {{promo.promoTitle}} {{promo.promoDescription}}. {{$productOrderCtrl.translations['antibody.pdp.commerceCard.promotion.learnmore']}}
产品信息
10930-1-AP
种属反应
宿主/亚型
分类
类型
抗原
偶联物
形式
浓度
纯化类型
保存液
内含物
保存条件
运输条件
产品详细信息
Immunogen sequence: TATLRPYLS AVRATLQAAL CLENFSSQVV ERHNKPEVEV RSSKELLLQP VTISRNEKEK VLIEGSINSV RVSIAVKQAD EIEKILCHKF MRFTMMRAEN FFILRRKPVE GYDISFLITN FHTEQMYKHK LVDFVIHFME EIDKEISEMK LSVNARARIV AEEFLKNF (1-168 aa encoded by BC012596)
靶标信息
This gene encodes one of seven subunits of the human Arp2/3 protein complex. This complex controls actin polymerization in cells and has been conserved throughout eukaryotic evolution. This gene encodes the p20 subunit, which is necessary for actin nucleation and high-affinity binding to F-actin. Alternative splicing results in multiple transcript variants. Naturally occurring read-through transcription exists between this gene and the downstream tubulin tyrosine ligase-like family, member 3, which results in the production of a fusion protein.
仅用于科研。不用于诊断过程。未经明确授权不得转售。
生物信息学
蛋白别名: 20 kD subunit of the Arp2/3 protein complex; actin related protein 2/3 complex, subunit 4, 20kDa; Actin-related protein 2/3 complex subunit 4; Arp2/3 complex 20 kDa subunit; arp2/3 protein complex subunit p20; MGC13544; p20-ARC
基因别名: 20kDa; 5330419I20Rik; AI327076; ARC20; ARPC4; DEVLO; P20-ARC
UniProt ID: (Human) P59998, (Mouse) P59999
Entrez Gene ID: (Human) 10093, (Mouse) 68089, (Rat) 297518